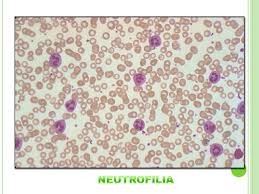
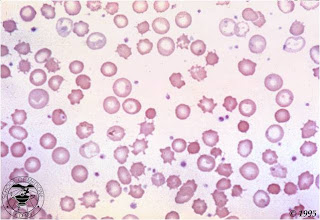
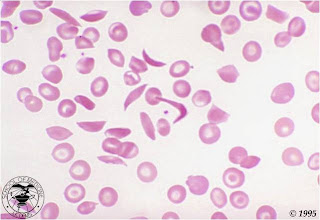
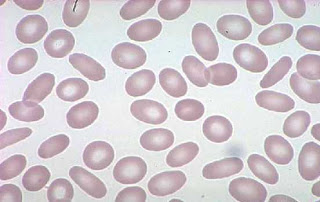
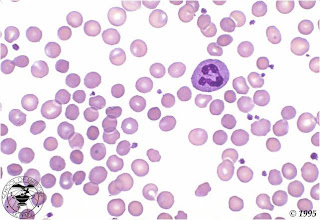
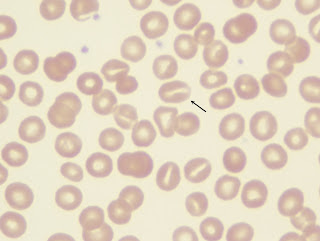
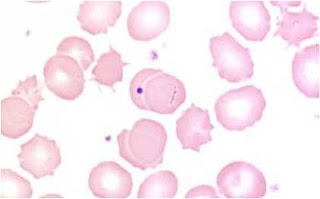
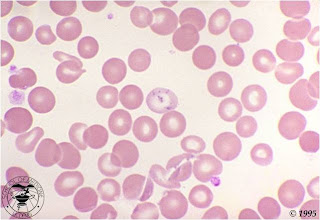
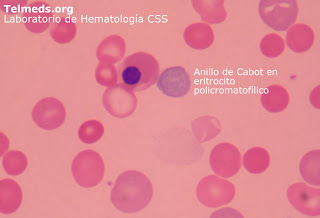

Biometria Hematica
La Biometria Hemática también denominada Hemograma, es uno de los estudios de rutina de mayor importancia, ya que la información que de aquí se deriva y nos proporciona una idea muy confiable del estado general de la salud del paciente, consta de 2 bloques:
-
Formula Roja: Determina los parámetros relacionados con el eritrocito.
-
Formula Blanca: Determina los parámetros relacionados con los leucocitos.
-
Formula Roja:La determinación de la fórmula roja se compone de los siguientes parámetros:
A. Hematocrito (Ht): Es el porcentaje de la sangre que está compuesta por eritrocitos.
B. Hemoglobina(Hb): Es determinada la cantidad de esta proteína expresada en g./dl.
C. Conteo eritrocítico(Eri): Es la cantidad total de eritrocitos circulantes por microlitro de sangre.
TEJIDO SANGUINEO
Tejido conjuntivo líquido que circula a través del aparato cardiovascular. Puedeconsiderarse un quinto tejido fundamental, su origen embriológico al igual que eldel tejido conjuntivo viene de la mesénquima y se denomina hematopoyesis. His stologicamente es un tejido que posee mucha sustancia intercelular o plasma y células. Su función es de transporte de oxígeno y dióxido de carbono, distribuciónde hormonas, mantenimiento de la homeostasis por medio del su efecto buffer, lacoagulación, y el control de la temperatura corporal, también distribuye otras sutancias nutritivas por el cuerpo.
Características generales:
-Líquido viscoso
-Ligeramente alcalino, ph 7,3 a 7,5
-Color rojo brillante a rojo oscuro dependiendo de la oxigenación
-Densidad 1055 a 1060-Coagula en reposo.
Los coagulantes y anticoagulantes la mantienen líquida.
cuando la sangre se coagula en un suero que es el plasma sin anticoagulantes y en el coagulo.
El hematocrito es el volumen de eritrocitos en una muestra de sangre y se obtienepor medio de la centrifugación para sedimentar las células y calculando elporcentaje de eritrocitos en la muestra. La muestra debe tener anticoagulante. Seve una cubierta tromboleucocitaria sobre las células sedimentadas que poseen las plaquetas y los leucocitos. sus valores bajos pueden indicar anemia o sangramiento interno.
La sangre tiene un 45% de celulas y un 55% de plasma.

PLASMA:
El plasma es la fracción líquida y acelular de la sangre, es decir, se obtiene al dejar a la sangre desprovista de células como los glóbulos rojos y los glóbulos blancos. Está compuesto por un 90% de agua, un 7% de proteinas y el 3% restante por grasa, glucosa , vitaminas, hormonas, oxigeno, gas carbónico y nitrogeno , además de productos de desecho del metabolismo como el acido urico. A estos se les pueden añadir otros compuestos como las sales y la urea. Es el componente mayoritario de la sangre, representando aproximadamente el 55% del volumen sanguíneo total, mientras que el 45% restante corresponde a los elemento formes (tal magnitud está relacionada con el hematocrito).
El suero, es el remanente del plasma sanguíneo una vez consumidos los factores hemostáticos por la coagulación de la sangre.

ALBUMINA:
El plasma es la fracción líquida y acelular de la sangre, es decir, se obtiene al dejar a la sangre desprovista de células como los glóbulos rojos y los glóbulos blancos. Está compuesto por un 90% deagua, un 7% de proteínas, y el 3% restante por grasa, glucosa, vitaminas, hormonas, oxígeno, gas carbónico y nitrógeno, además de productos de desecho del metabolismo como el ácido úrico. A estos se les pueden añadir otros compuestos como las sales y la urea. Es el componente mayoritario de la sangre, representando aproximadamente el 55% del volumen sanguíneo total, mientras que el 45% restante corresponde a los elementos formes (tal magnitud está relacionada con el hematocrito).
El suero, es el remanente del plasma sanguíneo una vez consumidos los factores hemostáticos por la coagulación de la sangre.

FIBRINOGENO:
El fibrinógeno es una proteína soluble del plasma sanguíneo precursor de la fibrina, su longitud es de 46 nm, su peso 340 kDa.
Es responsable de la formación de los coágulos de sangre. Cuando se produce una herida se desencadena la transformación del fibrinógeno en fibrina gracias a la actividad de la trombina.
Es una molécula fibrilar, que en sus extremos tiene cargas fuertemente negativas
Estos extremos, permiten la solubilidad del compuesto y también repelen a otras moléculas del compuesto, previniendo la agregación. Compuesto por tres pares de cadenas de polipéptidos que son, 2 cadenas Aα, 2 Bβ y 2γ (Aα,Bβ,γ)2 unidas por enlaces disulfuro, estas cadenas además están genéticamente ligadas y reguladas en forma coordinada en el ser humano.
Estas cadenas son sintetizadas en el hígado.

Gammaglobulinas:
La gamma globulina es un tipo de globulina denominada así por aparecer en último lugar al separar las proteínas del suero sanguíneo mediante una electroforesis. El principal tipo de gamma globulina es el de los anticuerpos o inmunoglobulinas (Igs), aunque algunas Igs no migran en esta fracción de la electroforesis.

Sangre:
La sangre es un tejido fluido que circula por capilares, venas y arterias de todos los vertebrados. Su color rojo característico es debido a la presencia del pigmento hemoglobínicocontenido en los eritrocitos.
Es un tipo de tejido conjuntivo especializado, con una matriz coloidal líquida y una constitución compleja. Tiene una fase sólida (elementos formes, que incluye a los leucocitos (o glóbulos blancos), los eritrocitos (o glóbulos rojos) y las plaquetas y una fase líquida, representada por elplasma sanguíneo.
Su función principal es la logística de distribución e integración sistémica, cuya contención en los vasos sanguíneos (espacio vascular) admite su distribución (circulación sanguínea) hacia casi todo el cuerpo.

- a: Glóbulos rojos o eritrocitos
- b: Glóbulo blanco: Neutrófilo
- c: Glóbulo blanco: Eosinófilo
- d: Glóbulo blanco: Linfocito
Hematopoyesis:
La hematopoyesis o hemopoyesis es el proceso de formación, desarrollo y maduración de los elementos formes de la sangre (eritrocitos, leucocitos y plaquetas) a partir de un precursor celular común e indiferenciado conocido como célula madre hematopoyética pluripotencial, unidad formadora de clones, hemocitoblasto o stem cell.
Las celulas madres que en el adulto se encuentran en la médula ósea son las responsables de formar todas las células y derivados celulares que circulan por la sangre.
Las células sanguíneas son degradadas por el bazo y los macrófagos del hígado. Este último, también elimina las proteínas y otras sustancias de la sangre.

ERITROCITOS:
Los eritrocitos, (también llamados glóbulos rojos ohematíes), son los elementos formes cuantitativamente más numerosos de la sangre. La hemoglobinaes uno de sus principales componentes, y su objetivo es transportar el oxígeno hacia los diferentes tejidos del cuerpo. Los eritrocitos humanos carecen de núcleo y de mitocondrias, por lo que deben obtener su energía metabólica a través de la fermentación láctica. La cantidad considerada normal fluctúa entre 4.500.000 (en la mujer) y 5.000.000 (en el hombre) por milímetro cúbico (o microlitro) de sangre, es decir, aproximadamente 1.000 veces más que los leucocitos.El exceso de glóbulos rojos se denomina policitemia y su deficiencia se llama anemia.

LEUCOCITOS: GRANULADOS.
Se generan en la medula osea.
Responsables de el control de infecciones
Existen dos tipos: Granulado y no granulados.
Los leucocitos se dividen en: neutrófilos, eosinófilos, basófilos, linfocitos y monocitos.
La fórmula leucocitaria corresponde al recuento porcentual de cada uno de ellos en sangre periférica. Tiene un gran valor clínico, si bien las alteraciones cuantitativas hay que referirlas siempre en términos absolutos.
Los leucocitos son fácilmente reconocibles en el frotis ya que son células nucleadas (a diferencia de las plaquetas y hematíes).
Granulocitos
Son leucocitos de 10-14 micras de diámetro. Su núcleo presenta diversas lobulaciones, por esa razón también se conocen como polimorfonucleares, y su citoplasma contiene granulación. En función del tipo de granulación se diferencian los tres subtipos de granulocitos: neutrófilos (granulación fina neutrófila),eosinófilos (granulación eosinófila: de color rosado oscuro) y basófilos(granulación basófila: color azul oscuro). Los precursores inmediatos se llaman cayados o bandas y se caracteriza por un núcleo menos segmentado.
Granulocitos
Son leucocitos de 10-14 micras de diámetro. Su núcleo presenta diversas lobulaciones, por esa razón también se conocen como polimorfonucleares, y su citoplasma contiene granulación. En función del tipo de granulación se diferencian los tres subtipos de granulocitos: neutrófilos (granulación fina neutrófila),eosinófilos (granulación eosinófila: de color rosado oscuro) y basófilos(granulación basófila: color azul oscuro). Los precursores inmediatos se llaman cayados o bandas y se caracteriza por un núcleo menos segmentado.
#GRANULOCITO NEUTROFILO.

#GRANULOSITO EOSINOFILO

#GRANULOSITO BASOFILO

BASOFILO:
Los granulocitos segmentados basófilos son células redondeadas cuyo tamaño oscila entre 10 y 13 μm. El núcleo, de cromatina densa, posee generalmente dos o tres lóbulos unidos por puentes cromatínicos, en ocasiones difíciles de visualizar dada la presencia de las numerosas granulaciones basófilas propias de esta célula. Los gránulos basófilos se disponen encima del núcleo. la granulación basófila, de tamaño entre 0.2 y 1 um, adquiere una coloración rojo-violácea oscura con las tinciones panópticas y tiene una forma poligonal. En ocasiones, los gránulos basófilos se disponen en el interior de vacuolas citoplasmáticas, imagen óptica que traduce la disolución parcial de estos gránulos tras las maniobras de fijación. La característica principal de los gránulos basófilos es su metacromasia con los colorantes azules (azul de metileno, azul de toluidina), con los que adquiere una tonalidad rojiza, mientras que el resto de las estructuras celulares se tintilde;en de color azul. La metacromasia se debe a la riqueza de estos gránulos en mucopolisacáridos ácidos sulfatados. Los gránulos basófilos también son ricos en histamina, heparina, glucógeno y determinados enzimas ( peroxidasa). Otro enzima a destacar es la omega exonucleasa, localizada en la zona intercelular del basófilo y mastocito y que es de gran utilidad para la identificación de basófilos degranulados presentes en ciertas hemopatías. A diferencia de los mastocitos, no contienen cloroacetatoesterasa; tampoco tienen fosfatasa alcalina. Otra característica diferencial entre los gránulos basófilos y los del mastocito es la hidrosolubilidad de los primeros, por lo que el citoplasma del basófilo aparece, a veces, con numerosas vacuolas que no son más que gránulos parcialmente extraídos.

Contiene un pequeño aparato de Golgi, algunas mitocondrias ,un extenso RER (Retículo Endoplasmático Rugoso) y pequeñas inclusiones de glucógeno.
* Los gránulos de los basófilos son gruesos pero escasos.
* Son los menos numerosos, ya que constituyen sólo el 0,5% del total.
* Tienen una activa participación en la respuesta inmunitaria, a través de la liberación de histamina, serotonina en bajas concentraciones, y otras sustancias químicas.
* Tiene gránulos de dos clases:
* Gránulos azurófilos: Contienen lisosomas, que a su vez estos contienen hidrolasas ácidas.
* Gránulos específicos o secundarios: Contienen histamina (vasodilatador), heparán sulfato (vasodilatador), heparina (anticoagulante) y leucotrienos (hacen contraer el músculo lisode las vías aéreas).
* Poseen receptores de IgE (inmunoglobulina E), aquella inmunoglobulina relacionada con las alergias. Es por eso que el basófilo participa en la respuesta inflamatoria.
* Ahora se revela que los basófilos inician y amplifican las reacciones alérgicas de tal modo que una vez iniciada por el contacto con el alérgeno se volverían difíciles de controlar.
EOSINOFILO:
Los granulocitos segmentados eosinófilos tienen un tamañ semejante a los neutrófilos, se caracterizan morfológicamente por contener en su citoplasma gránulos acidófilos. Tienen una forma redondeada, tamaño entre 0.5 y 1.5 μm, ocupan todo el citoplasma de la célula y se tiñen de color naranja o marrón anaranjado con las coloraciones panópticas. A diferencia de los gránulos basófilos nunca se disponen por encima del núcleo. Desde el punto de vista ultraestructural, los eosinófilos poseen distintos tipos de granulación : 1/ granulación primaria, donde se localiza la lipofosfolipas, también denominada proteína del cristal de Charcot Leyden. estos gránulos no tienen centro cristaloide y constituyen aproximadamenten un 5% de la granulación del eosinófilo. 2/ Una granulación secundaria, con centro cristaloide, que representa más del 95% de la granulación en el eosinófilo maduro y 3/ microgránulos o estructuras tubulovesiculares que son ricos en fosfatasa ácida y proteínas catiónicas. citoquímicamente se caracterizan por poseer gran cantidad de mieloperoxidasa, fosfatasa ácida y arilsulfatasa. La peroxidasa se dispone fundamentalmente en la matriz del gránulo y posee características diferenciales bioquímicas, antigénicas y ontogénicas con respecto a la peroxidasa de la serie neutrófila. también contienen proteínas catiónicas y mucosustancias sulfatadas; poseen, asimismo, un alto contenido en fosfolipasa y lisofosfolipas. Por el contrario, está desprovisto de fosfatasa alcalina y lactoferrina. Su papel biológico principal es el de modulador de la reacción anafiláctica al ser capaces de inactivar sustancias liberadas por los mastocitos y el control de la infestación por ciertos parásitos, cuyo ataque no tiene lugar por mecanismos de fagocitosis, sino por adherencia y subsiguiente citotoxicidad al segregar diversas sustancias nocivas.

NEUTROLIGO SEGMENTADO:
Los granulocitos segmentados neutrófilos son células redondeadas, de tamaño entre 12 y 14 um. Su núcleo está segmentado en 2 a 5 lóbulos, unidos por unos finos puentes cromatínicos. El citoplasma contiene numerosos gránulos neutrófilos que se tiñen de color marrón con las coloraciones panópticas habituales, así como cierto número de gránulos primarios o azurófilos dificilmente visibles al quedar enmascarados por los neutrófilos. Citoquímicamente los granulocitos segmentados neutrófilos son positivos a la mieloperoxidasa, fosfatasa ácida, cloroacetatoesterasa, catepsina G y elastasa. Contiene, asimismo, material PAS positivo y lactoferrina, entre otras sustancias detectadas citoquímicamente.
Tamaño: 10-15 mm
Nucleo: 2-5 lobulos conectados por filamentos delgado sin cromatina visible
Nucléolos: no se observan
Cromatina: grupos gruesos
Citoplasma: azul palido o rosa
Granulos primarios: escasos
Secundarios: abundantes
Relación n/c: predomino el citoplasma
Intervalo de referencia
Medula osea: 3-11%
Sangre periférica: 50-70%

NEUTROFILO BANDA:
Tamaño: 10-15 mm
Núcleos: conformado de Cos. Estrechado pero no en forma de filamentos delgado
NOTA: la cromatina debe ser visible en a porción estrecha, puede estar doblado por si mismo
Nucléolo: no se observa
Crematina: grumos gruesos
Citoplasma: azul palido o rosa
Granulos
Primarios: escasos
Secundarios: abundantes
Relación n/c: predomina
Intervalo de referencia
Medula ósea: 17-33%
Sangre periférica: 0-5%

Linfocitos
Son células mononucleadas cuyo tamaño varía entre 6-8 a 10-20 micras dependiendo de su estado de activación. Son los principales efectores de la respuesta inmune específica. Su núcleo es redondo y su citoplasma es en general escaso, basófilo y, en ocasiones, contiene una discreta granulación azurófila.

Tamaño:7-18mm
Núcleo: redondo, ovalado, puede ser ligeramente identada
Nucléolos: ocasionales
Cromotina: condensada o ligeramente condensada
Citoplasma: escaso o moderado celeste cielo; puede presentar vacuolas
NOTA: la diferencia de tamaño entre infectados pequeños y grande se debe principalmente a la mayor cantidad de citoplasma
Granulos: escasos azurofilos (violetas)
Relación n/c: 3-5%
Intervalos de referencia
Medula ósea: 5-15%
Sangre periférica: 20-40%
Monocitos
Son células de tamaño grande pero variable. Su núcleo tiene un aspecto reniforme, de cromatina laxa y con presencia de una granulación azurófila fina en su citoplasma. Su función es fagocitar restos celulares y partículas, lo que los convierte en elementos clave para la respuesta inmunitaria no específica.
Tamaño: 12-20mm
Nucleo: variable: puede ser redonde, con fewcuencia presenta plegues de aspecto similar a las circunviluciones del cerebro
Nucléolos: no se observan
Gromatria: similar al encaje
Citoplasma: azul grisáceo, pueden presentar pseodopodos
Granulos: muchos granulos finos que dan con frecuencia el aspecto de vidrio esmerilado
Vacuolas ausentes: a numerosas
Relacion n/c: variable
Intervalo de frecuencia
Medula osea: 2%
Sangre periférica: 3-11%

Atendiendo a las características expuestas, también se clasifica a los leucocitos en:
- Granulocitos: neutrófilos, eosinófilos y basófilos.
- Agranulocitos: monocitos y linfocitos.
- Polimorfonucleares: neutrófilos, eosinófilos y basófilos.
- Mononucleares: monocitos y linfocitos.
- Fagocitos: neutrófilos y monocitos
TROMBOPOYESIS:
Las plaquetas se originan por fragmentación de los megacariocitos de la médula ósea. El proceso de trombopoyesis dura unos 7 días. Se inicia a partir de una célula progenitora multipotencial común de las series eritroide, mieloide y megacariocítica (CFU-GEMM). De esta célula derivan las células progenitoras comprometidas para megacariocitos (CFU-M). Tras una fase proliferativa, las células progenitoras sufren una división nuclear sin división celular, dando lugar a un megacarioblasto que es una célula gigante con un gran núcleo multilobulado y una carga cromosómica poliploidea. Una vez conformado el proceso madurativo la célula se transforma en promegacariocito y posteriormente en megacariocito, que sufrirá un proceso en el cual empezará a duplicar su ADN sin llegar a fragmentarse y a llenarse de organelas típicas de las plaquetas. Posteriormente se fragmentará y originará estas plaquetas, que abandonarán la médula ósea. Cada megacariocito produce el orden de entre 2000 y 7000 plaquetas, producción que estará regulada por la trombopoyetina, una hormona con funciones similares a la eritropoyetina y que estimulará la trombopoyesis.

ANTICOAGULANTES:

PUNCION CAPILAR:
La sangre de esta punción es una mezcla de sangre de arteriolas y venosa; Es de particular utilidad en las siguientes circunstancias:
-*Si la punción venosa es peligrosa para el paciente
-*No se puede accesar a venas recomendadas
-*Las venas están siendo usadas para administrar medicamentos
-*El volumen de sangre requerido no justifica una extracción
Aplicables
1.- Neonatos
2.- Lactantes
3.- Niños
4.- Adultos con quemaduras severas
5.- En caso de terapias intravenosas
Lancetas
Es el instrumento usado para extraer una pequeña muestra de sangre por medio de una leve punción

Procedimiento de Punción Capilar
1.- Una vez localizado el sitio de punción, puede dar un ligero masaje en el área, para concentrar la sangre
2.- Limpie el sitio con alcohol etílico o isopropilico al 70%
3.- Con una mano sostenga el dedo o area a puncionar y con la otra sostenga la lanceta
4.- Haga una punción con la lanceta, realizando un movimiento rápido, firme y profundo
5.- Después de puncionar, descartar la primer gota de sangre, que contiene liquido tisular, limpiando la zona con el algodón
6.- Presione el dedo para hacer salir la sangre procurando sea de manera ininterrumpida
7.- Una vez tomada la muestra, sellar los tubos capilares con sellador o los microtubos con su tapa
8.- Los microtubos y capilares con anticoagulantes, deben ser invertidos suavemente por lo menos 10 veces para evitar su coagulación
9.- Coloque el algodon sobre el sitio puncionado haciendo presión para parar el sangrado

PUNCION VENOSA
La punción venosa es una técnica que nos permite acceder al torrente sanguíneo con fines determinados como por ejemplo extraer sangre, administrar medicamentos, derivados sanguíneos, etc.
El organismo utiliza la sangre para el transporte de oxígeno, alimento, residuos y otros materiales que hay en el interior del cuerpo y para regular la temperatura corporal, los líquidos y el equilibrio ácido-base. Debido a que la sangre se utiliza para múltiples funciones dentro del cuerpo, los exámenes de sangre o de sus componentes pueden suministrar indicios claves para el diagnóstico de muchas condiciones médicas.
Antes de acceder a puncionar se debe considerar una serie de paramentos relevantes para el éxito de la punción, tales como:
• Las condiciones físicas y psicológicas que trae el paciente
• La edad
• Considerar un tiempo adecuado para explicar el procedimiento lo que disminuirá la ansiedad del paciente.
• Considerar las condiciones en que será tomada la muestra, sentado o en camilla.
• Necesidad de pedir ayuda antes de iniciar el procedimiento
• Verificar que en el sitio a puncionar la piel se encuentra indemne y lejos de los focos de infección.
Las venas más utilizadas para la venopunción están localizadas en el área ante cubital:
1. Vena Cubital: Es la más larga y gruesa de todas y es la preferida por bordear la musculatura del brazo.
2. Vena Cefálica: Tiene iguales características de la anterior, pero es un poco menos gruesa.
3. Vena Basílica: Es más pequeña que las anteriores. Esta vena está cerca de la arteria braquial, por lo que su punción es riesgosa y su área es más sensible y dolorosa para el paciente.
Nunca debemos puncionar en:
• Piel con lesiones
• Hematomas
• Quemaduras
• Cicatrices
• Brazo del lado con mastectomía reciente
• Venas tortuosas
• Brazo con infusión venosa

Arteria, Vena y Capilar.

PUNCION ARTERIAL.
Generalmente, la sangre se extrae de una arteria en la muñeca, aunque también puede sacarse de una arteria de la parte interior del codo, la ingle u otro sitio. Los latidos cardíacos (pulso) se sienten presionando en el área sobre una arteria. Si la sangre se extrae de la muñeca, el médico generalmente verifica el pulso para asegurarse de que la sangre esté fluyendo a la mano desde las arterias principales en el antebrazo (arterias radial y cubital).
El procedimiento es como sigue:
- Se limpia el área con un antiséptico.
- Se introduce una aguja. Se puede inyectar o aplicar una pequeña cantidad de anestésico antes de introducir la aguja.
- La sangre fluye hacia una jeringa de recolección especial.
- Se retira la aguja después de que se ha recogido suficiente sangre.
- Se aplica presión al sitio de punción durante un período de cinco a diez minutos para detener el sangrado. Durante este tiempo, se revisa para estar seguro de que el sangrado se detenga.
.jpg)
HEMOGLOBINAS:
|
La hemoglobina es una heteroproteína de la sangre, de peso molecular 68.000 (68 kD), de color rojo característico, que transporta el oxígeno desde los órganos respiratorios hasta los tejidos, en mamíferos, ovíparos y otros animales.
|
Tipos de hemoglobina
Hemoglobina A o HbA es llamada también hemoglobina del adulto o hemoglobina normal, representa aproximadamente el 97% de la hemoglobina degradada en el adulto, formada por dos globinas alfa y dos globinas beta.
Hemoglobina A2: Representa menos del 2,5% de la hemoglobina después del nacimiento, formada por dos globinas beta y dos globinas delta, que aumenta de forma importante en la beta-talasemia, al no poder sintetizar globinas beta.
Hemoglobina s: Hemoglobina alterada genéticamente presente en la Anemia de Células Falciformes. Afecta predominantemente a la población afroamericana y amerindia.
Hemoglobina t
Hemoglobina f: Hemoglobina característica del feto.
Oxihemoglobina: Representa la hemoglobina que se encuentra unida al oxígeno normalmente ( Hb+O2)
Metahemoglobina: Hemoglobina con grupo hemo con hierro en estado férrico, Fe (III). Ésta no se une al oxígeno, se produce por una enfermedad congénita en la cual hay deficiencia de metahemoglobina reductasa, la cual mantiene el hierro como Fe(III).
Carbaminohemoglobina: se refiere a la hemoglobina unida al CO2 después del intercambio gaseoso entre los glóbulos rojos y los tejidos (Hb+CO2).
Carboxihemoglobina: Hemoglobina resultante de la unión con el CO. Es letal en grandes concentraciones (40%). El CO presenta una afinidad 200 veces mayor que el Oxígeno por la Hbdesplazándolo a este fácilmente produciendo hipoxia tisular, pero con una coloración cutánea normal (produce coloración sanguínea fuertemente roja) (Hb+CO).
Hemoglobina glucosilada: presente en patologías como la diabetes, resulta de la unión de la Hb con carbohidratos libres unidos a cadenas carbonadas con funciones ácidas en el carbono 3 y 4.
Mioglobina: Hemoglobina presente en "el" músculo.
También se encuentran hemoglobinas embrionales: Gower 1, Gower 2 y Portland. Sólo están presentes en el embrión.
Son valores de referencia: Para Hombres: 16,0 +- 2,0. Para Mujeres: 14,0 +- 2,0

HEMATOCRITO:
Es un examen de sangre que mide el porcentaje del volumen de toda la sangre que está compuesta de glóbulos rojos. Esta medición depende del número de glóbulos rojos y de su tamaño.
El hematocrito casi siempre se ordena como parte de un conteo sanguíneo completo (hemograma).

INDICES ERITROCITARIOS:
Indices eritrocitarios

ALTERACIONES EN LOS ERITROCITOS:
FORMULA BLANCA:
La serie blanca está compuesta por los Leucocitos o Glóbulos blancos. Los leucocitos forman parte importante del sistema inmune, se dividen en 2 grandes grupos: 1) Neutrófilos segmentados y 2) Linfocitos.
Los leucocitos pueden verse alterados en múltiples padecimientos, principalmente en aquellos donde existen procesos inflamatorios (infecciones, enfermedades autoinmunes como Lupus y Artritis, enfermedades oncológicas como cáncer)
Sus valores pueden estar incrementados (Leucocitosis) o disminuidos (leucopenia) aunque la mayoría de las veces estos valores pueden estar alterados por infecciones, no son la única causa.

NEUTROFILIA:
Se refiere a la elevación de neutrófilos o segmentados por arriba de sus valores normales para la edad, aunque generalmente la neutrofilia se asocia con procesos infecciosos no es la única causa. Cualquier proceso inflamatorio podría dar elevación de neutrofilos, y aunque su elevación en procesos infecciosos normalmente se asocia a bacterias, las infeciones virales también pueden elevar los neutrofilos.
NEUTROPENIA:
Es la disminución de la cifra total de neutrófilos generalmente por debajo de 1,500 neutrofilos totales, puede estar asociada a procesos infecciosos, problemas hematológicos, neoplasia o cáncer, efecto de medicamentos como la quimioterapia que reciben los niños con cáncer. La neutropenia puede predisponer a infecciones al paciente dado que los neutrofilos son unas de las principales líneas de defensa ante las infecciones. Entre menor sea el numero de neutrofilos y mayor sea el tiempo que persistan con valores bajos, mayor será la posibilidad de aquirir procesos infecciosos asociados los cuales pueden incluir infecciones graves y oportunistas.

BANDEMIA:
Las bandas son una línea celular derivada de los neutrofilos, se consideran neutrofilos inmaduros, por decirlo así que salieron de la medula ósea antes de tiempo, es normal encontrar un porcentaje de estos en sangre, generalmente menor al 10%.
La elevación anormal de las bandas se denomina bandemia, y se presenta cuando existe algún proceso inflamatorio como una infección, donde el organismo en su intento por mandar mayor cantidad de leucocitos (defensas) al sitito de infección saca neutrofilos inmaduros (bandas) por lo que el porcentaje de estas se eleva a más del 10% del total de leucocitos

LINFOCITOSIS:
Elevación de linfocitos por arriba de los valores normales para la edad, la mayoría de las veces la linfocitosis se asocia a infecciones del tipo viral, aunque no es exclusiva, la elevación anormal de linfocitos se puede ver asociada a enfermedades hematológicas.


LINFOPENIA:
Disminución de la cuenta de leucocitos por debajo de los valores normales, normalmente menor a 1,500 linfocitos totales. La linfopenia puede estar asociada a procesos infecciosos, aunque también es común en enfermedades autoinmunes como el Lupus eritemasos sistémico, de igual manera algunas enfermedades hemato-oncologicas pueden presentarla.

PLAQUETAS:
Se encargan de controlar sangrados en el cuerpo, conglomerándose y formando pequeños tapones, mandan señales y desencadenan mecanismos que culminan con formación de coágulos para parar sangrados o hemorragias. Prácticamente son los únicos componentes de la sangre que su valor normal no varía desde el nacimiento hasta la edad adulta y va de 150,000 a 450,000.

TROMPOCITOPENIA O PLAQUETOPENIA:
Valores de plaquetas por debajo de 150,000, la trombocitopenia se puede ver en procesos infecciosos tanto por virus y bacterias (dengue, sepsis, purpura trombocitopenica idiopática) por consumo en hemorragias graves, por destrucción (hemolisis) como en el síndrome urémico hemolítico.


Trombocitosis o plaquetosis:
Es el aumento de plaquetas por arriba de los valores normales (450,000) se asocia en muchas ocasiones a procesos infecciosos, la mayoría en el periodo de recuperación, está presente en niños con enfermedad de Kawasaki regularmente en la 2ª semana de evolución, se ve en paciente con procesos neumónicos ya consolidados, los valores puede llegar a ser muy elevados por arriba de 1,000,000 de plaquetas, cuando estos valores se elevan demasiado puede ocasionar formación de coágulos y en algunos casos está indicado la administración de acido acetil salicílico (aspirina) para prevenir la formación de esto.

PANCITOPENIA:
Se refiere a que tiene las 3 líneas celulares afectadas (serie blanca (leucocitos) serie roja (hb) y las plaquetas). Encontrar pancitopenia es algo de gravedad en cualquier paciente y requiere de estudios a fondo si es que se desconoce la causa. Puede verse asociada en pacientes con cáncer o leucemia bien sea en el debut de su enfermedad o como consecuencia de la quimioterapia administrada, también se puede encontrar en paciente que cursan con anemia aplásica (la medula ósea deja de funcionar y se interrumpe la producción de todas las células que produce).

BICITOPENIA:
Se refiere a la afectación de 2 de las 3 líneas celulares (serie blanca (leucocitos) serie roja (hb) y las plaquetas). Si se ven afectados los leucocitos y las plaquetas y además hay fiebre puede tratarse de un proceso infeccioso como el Dengue, cito o una infección bacteriana grave como sepsis. Las enfermedades hemato-oncológicas como la leucemia también pueden producir bicitopenia.
.jpg)
Etiquetas
La lista de etiquetas está vacía.